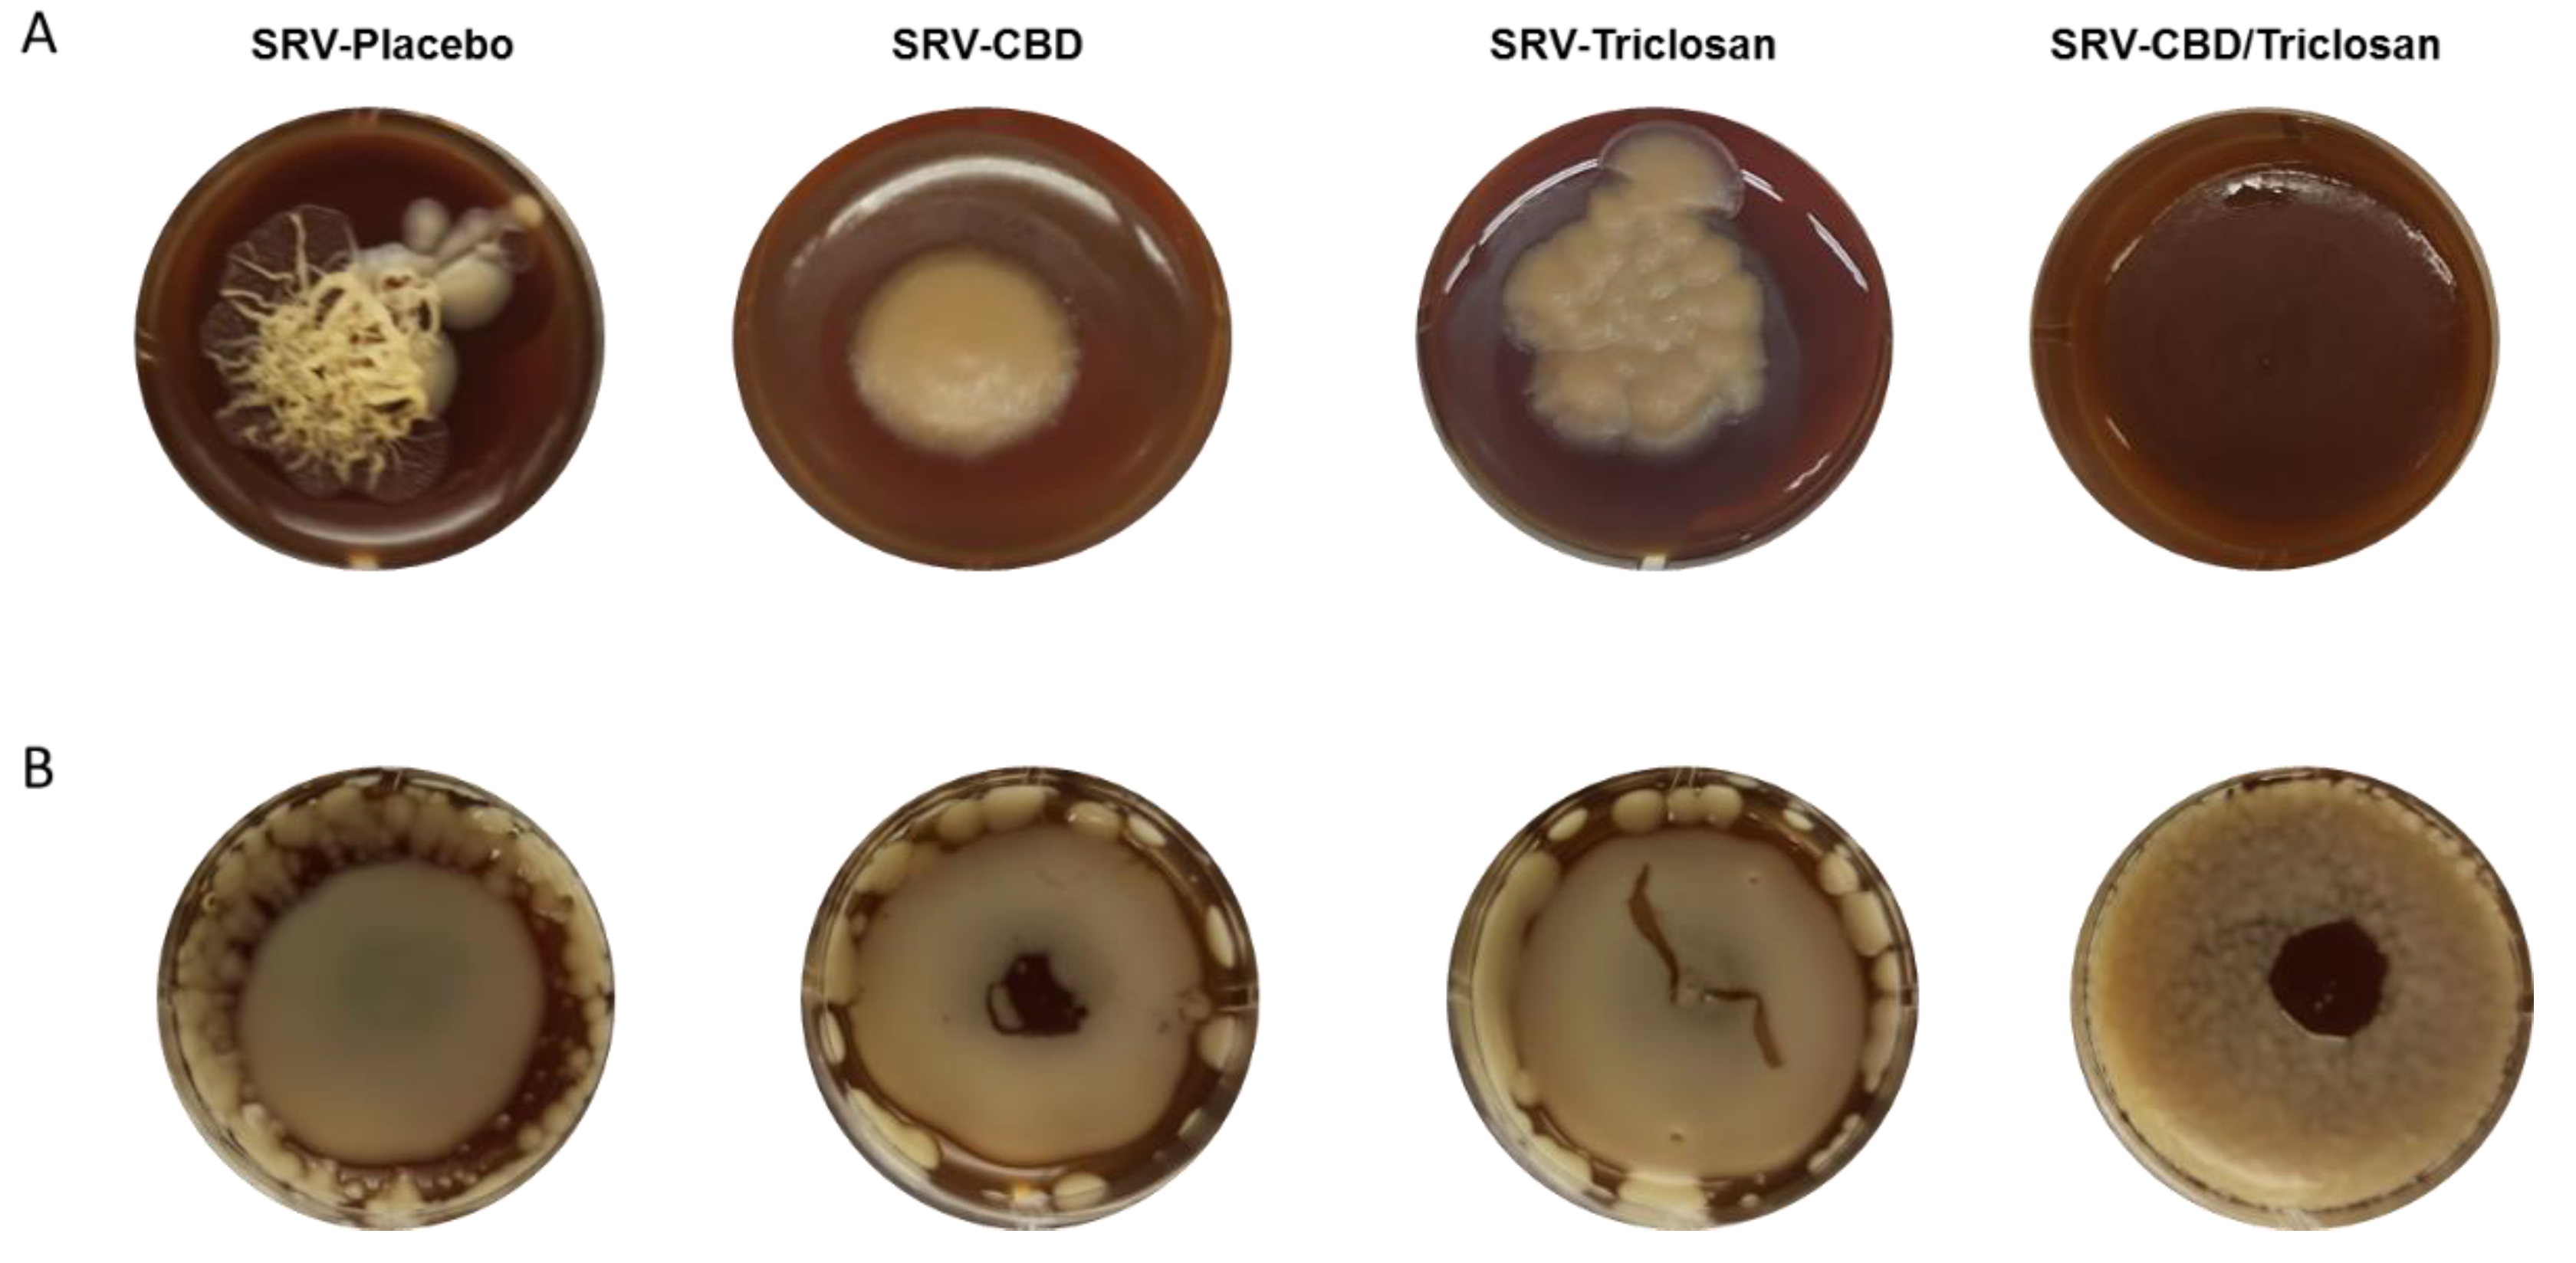
Pharmaceutics 14 01624 g005 Pharmaceutics 14 01624 g005

Potential Combinatory Effect of Cannabidiol and Triclosan Incorporated into Sustained Release Delivery System against Oral Candidiasis
Abstract
1. Introduction
2. Materials and Methods
2.1. Materials
2.2. Preparation of the SRV
2.3. Dissolution Testing of SRV-CBD/Triclosan
2.4. Quantification of the Active Ingredients
2.5. Coating Persistence on the Teeth
2.6. Fungal Strains and Growth Conditions
2.7. The Effect of SRVs on Biofilm Formation on Plastic Surfaces
2.8. The Effect of SRVs on Preformed Biofilms on Plastic Surfaces
2.9. The Effect of SRVs on Biofilm Formation and Hyphae Formation on Agar
2.10. Ex Vivo Tooth Model
2.11. Cytotoxicity Assay
2.12. Statistical Analysis
3. Results
3.1. The Drug Release from SRV-CBD/Triclosan
3.2. The Coating Resilience
3.3. Inhibitory Effect on Biofilm Formation in Plastic Model
3.4. Eradication of Matured Biofilm in the Plastic Model
3.5. Long-Term Inhibition of Biofilm Formation and Fungal Morphology Alteration on Agar
3.6. Biofilm Inhibition in Ex Vivo Tooth Model
3.7. SRV-CBD/Triclosan Does Not Exhibit Cytotoxicity towards Mammalian Cells
4. Discussion
Author Contributions
Funding
Data Availability Statement
Acknowledgments
Conflicts of Interest
References
- Mayer, F.; Wilson, D.; Hube, B. Candida albicans pathogenicity mechanisms. Virulence 2013, 4, 119–128. [Google Scholar] [CrossRef] [PubMed]
- Feldman, M.; Al-Quntar, A.; Polacheck, I.; Friedman, M.; Steinberg, D. Therapeutic potential of thiazolidinedione-8 as an antibiofilm agent against Candida albicans. PLoS ONE 2014, 9, e93225. [Google Scholar] [CrossRef] [PubMed]
- Pfaller, M.A.; Diekema, D.J. Epidemiology of invasive candidiasis: A persistent public health problem. Clin. Microbiol. Rev. 2007, 20, 133–163. [Google Scholar] [CrossRef]
- Blankenship, J.R.; Mitchell, A.P. How to build a biofilm: A fungal perspective. Curr. Opin. Microbiol. 2006, 9, 588–594. [Google Scholar] [CrossRef] [PubMed]
- Feldman, M.; Sionov, R.V.; Mechoulam, R.; Steinberg, D. Anti-biofilm activity of cannabidiol against Candida albicans. Microorganisms 2021, 9, 441. [Google Scholar] [CrossRef] [PubMed]
- Feldman, M.; Shenderovich, J.; Al-Quntar, A.A.A.; Friedman, M.; Steinberg, D. Sustained release of a novel anti-quorum-sensing agent against oral fungal biofilms. Antimicrob. Agents Chemother. 2015, 59, 2265–2272. [Google Scholar] [CrossRef]
- MacCallum, C.A.; Russo, E.B. Practical considerations in medical cannabis administration and dosing. Eur. J. Intern. Med. 2018, 49, 12–19. [Google Scholar] [CrossRef]
- Pacher, P.; Kogan, N.M.; Mechoulam, R. Beyond THC and endocannabinoids. Annu. Rev. Pharmacol. Toxicol. 2020, 60, 637–659. [Google Scholar] [CrossRef]
- Pisanti, S.; Malfitano, A.M.; Ciaglia, E.; Lamberti, A.; Ranieri, R.; Cuomo, G.; Abate, M.; Faggiana, G.; Proto, M.C.; Fiore, D. Cannabidiol: State of the art and new challenges for therapeutic applications. Pharmacol. Ther. 2017, 175, 133–150. [Google Scholar] [CrossRef] [PubMed]
- Kosgodage, U.S.; Matewele, P.; Awamaria, B.; Kraev, I.; Warde, P.; Mastroianni, G.; Nunn, A.V.; Guy, G.W.; Bell, J.D.; Inal, J.M. Cannabidiol is a novel modulator of bacterial membrane vesicles. Front. Cell. Infect. Microbiol. 2019, 9, 324. [Google Scholar] [CrossRef]
- Stahl, V.; Vasudevan, K. Comparison of Efficacy of Cannabinoids versus Commercial Oral Care Products in Reducing Bacterial Content from Dental Plaque: A Preliminary Observation. Cureus 2020, 12, e6809. [Google Scholar] [CrossRef]
- Wassmann, C.S.; Højrup, P.; Klitgaard, J.K. Cannabidiol is an effective helper compound in combination with bacitracin to kill Gram-positive bacteria. Sci. Rep. 2020, 10, 4112. [Google Scholar] [CrossRef] [PubMed]
- Karas, J.A.; Wong, L.J.; Paulin, O.K.; Mazeh, A.C.; Hussein, M.H.; Li, J.; Velkov, T. The antimicrobial activity of cannabinoids. Antibiotics 2020, 9, 406. [Google Scholar] [CrossRef] [PubMed]
- Bruni, N.; Della Pepa, C.; Oliaro-Bosso, S.; Pessione, E.; Gastaldi, D.; Dosio, F. Cannabinoid delivery systems for pain and inflammation treatment. Molecules 2018, 23, 2478. [Google Scholar] [CrossRef]
- Sionov, R.V.; Steinberg, D. Anti-Microbial Activity of Phytocannabinoids and Endocannabinoids in the Light of Their Physiological and Pathophysiological Roles. Biomedicines 2022, 10, 631. [Google Scholar] [CrossRef]
- Appendino, G.; Gibbons, S.; Giana, A.; Pagani, A.; Grassi, G.; Stavri, M.; Smith, E.; Rahman, M.M. Antibacterial cannabinoids from Cannabis sativa: A structure-activity study. J. Nat. Prod. 2008, 71, 1427–1430. [Google Scholar] [CrossRef] [PubMed]
- Stewart, B.; Shibli, J.A.; Araujo, M.; Figueiredo, L.C.; Panagakos, F.; Matarazzo, F.; Mairink, R.; Onuma, T.; Faveri, M.; Retamal-Valdes, B. Effects of a toothpaste containing 0.3% triclosan in the maintenance phase of peri-implantitis treatment: 2-Year randomized clinical trial. Clin. Oral Implant. Res. 2018, 29, 973–985. [Google Scholar] [CrossRef] [PubMed]
- Ribeiro, F.V.; Casati, M.Z.; Casarin, R.C.; Corrêa, M.G.; Cirano, F.R.; Negri, B.M.; Pimentel, S.P. Impact of a triclosan-containing toothpaste during the progression of experimental peri-implant mucositis: Clinical parameters and local pattern of osteo-immunoinflammatory mediators in peri-implant fluid. J. Periodontol. 2018, 89, 203–212. [Google Scholar] [CrossRef]
- Monteiro, M.F.; Tonelli, H.; Reis, A.A.; Casati, M.Z.; Silvério, K.G.; Nociti Junior, F.H.; Sallum, E.A.; Casarin, R.C.V. Triclosan toothpaste as an adjunct therapy to plaque control in children from periodontitis families: A crossover clinical trial. Clin. Oral Investig. 2020, 24, 1421–1430. [Google Scholar] [CrossRef]
- Rathke, A.; Staude, R.; Muche, R.; Haller, B. Antibacterial activity of a triclosan-containing resin composite matrix against three common oral bacteria. J. Mater. Sci. Mater. Med. 2010, 21, 2971–2977. [Google Scholar] [CrossRef] [PubMed]
- Steinberg, D.; Tal, T.; Friedman, M. Sustained-release delivery systems of triclosan for treatment of Streptococcus mutans biofilm. J. Biomed. Mater. Res. Part B Appl. Biomater. 2006, 77, 282–286. [Google Scholar] [CrossRef] [PubMed]
- Grin, A.; Moor, E.; Friedman, M. Sustained release of doxycycline as matrix metalloproteinase inhibitor for treatment of chronic periodontal diseases: In vitro evaluation. J. Drug Deliv. Sci. Technol. 2009, 19, 295–300. [Google Scholar] [CrossRef]
- Kanjickal, D.G.; Lopina, S.T. Modeling of drug release from polymeric delivery systems—A review. Crit. Rev. Ther. Drug Carr. Syst. 2004, 21, 345–386. [Google Scholar] [CrossRef]
- Benitez, L.L.; Carver, P.L. Adverse effects associated with long-term administration of azole antifungal agents. Drugs 2019, 79, 833–853. [Google Scholar] [CrossRef] [PubMed]
- Wiederhold, N.P. The antifungal arsenal: Alternative drugs and future targets. Int. J. Antimicrob. Agents 2018, 51, 333–339. [Google Scholar] [CrossRef]
- George, A.M.; Kalangi, S.K.; Vasudevan, M.; Krishnaswamy, N. Chlorhexidine varnishes effectively inhibit Porphyromonas gingivalis and Streptococcus mutans—An in vivo study. J. Indian Soc. Periodontol. 2010, 14, 178. [Google Scholar] [CrossRef]
- Steinberg, D.; Moldovan, M.; Molukandov, D. Testing a degradable topical varnish of cetylpyridinium chloride in an experimental dental biofilm model. J. Antimicrob. Chemother. 2001, 48, 241–243. [Google Scholar] [CrossRef] [PubMed][Green Version]
- Steinberg, D.; Rozen, R.; Klausner, E.; Zachs, B.; Friedman, M. Formulation, development and characterization of sustained release varnishes containing amine and stannous fluorides. Caries Res. 2002, 36, 411–416. [Google Scholar] [CrossRef] [PubMed]
- Czerninski, R.; Sivan, S.; Steinberg, D.; Gati, I.; Kagan, L.; Friedman, M. A novel sustained-release clotrimazole varnish for local treatment of oral candidiasis. Clin. Oral Investig. 2010, 14, 71–78. [Google Scholar] [CrossRef] [PubMed]
- Czerninski, R.; Pikovsky, A.; Gati, I.; Friedman, M.; Steinberg, D. Comparison of the efficacy of a novel sustained release clotrimazole varnish and clotrimazole troches for the treatment of oral candidiasis. Clin. Oral Investig. 2015, 19, 467–473. [Google Scholar] [CrossRef] [PubMed]
- Sionov, R.V.; Gati, I.; Kirmayer, D.; Friedman, M.; Steinberg, D.; Gross, M. Voice Prosthesis Coated with Sustained Release Varnish Containing Clotrimazole Shows Long-Term Protection against Candida albicans: An In Vitro Study. Molecules 2021, 26, 5395. [Google Scholar] [CrossRef] [PubMed]
- Mensch, K.; Pongracz, J.; Nagy, A.; Kristof, K.; Bechir, A.; Pacurar, M.; Nagy, G. Preventive and Therapeutic Effects of Chlorhexidine Containing Varnish on Candida Biofilm. Rev. Chim. 2017, 68, 2808–2811. [Google Scholar] [CrossRef]
- Martins, K.V.; de Lacerda Gontijo, S.M. Treatment of denture stomatitis: Literature review. Rev. Bras. Odontol. 2017, 74, 215–220. [Google Scholar] [CrossRef]
- Gerami-Nejad, M.; Zacchi, L.F.; McClellan, M.; Matter, K.; Berman, J. Shuttle vectors for facile gap repair cloning and integration into a neutral locus in Candida albicans. Microbiology 2013, 159, 565. [Google Scholar] [CrossRef]
- Feldman, M.; Tanabe, S.; Howell, A.; Grenier, D. Cranberry proanthocyanidins inhibit the adherence properties of Candida albicans and cytokine secretion by oral epithelial cells. BMC Complement. Altern. Med. 2012, 12, 6. [Google Scholar] [CrossRef] [PubMed]
- Nett, J.E.; Marchillo, K.; Spiegel, C.A.; Andes, D.R. Development and validation of an in vivo Candida albicans biofilm denture model. Infect. Immun. 2010, 78, 3650–3659. [Google Scholar] [CrossRef] [PubMed]
- Gomes, P.N.; da Silva, W.J.; Pousa, C.C.; Narvaes, E.A.O.; Cury, A.A.D.B. Bioactivity and cellular structure of Candida albicans and Candida glabrata biofilms grown in the presence of fluconazole. Arch. Oral Biol. 2011, 56, 1274–1281. [Google Scholar] [CrossRef] [PubMed]
- Privett, B.J.; Nutz, S.T.; Schoenfisch, M.H. Efficacy of surface-generated nitric oxide against Candida albicans adhesion and biofilm formation. Biofouling 2010, 26, 973–983. [Google Scholar] [CrossRef]
- Powderly, W.G.; Gallant, J.E.; Ghannoum, M.A.; Mayer, K.H.; Navarro, E.E.; Perfect, A.J.R. Clinical Perspective Oropharyngeal Candidiasis in Patients with HIV: Suggested Guidelines for Therapy. AIDS Res. Hum. Retrovir. 1999, 15, 1619–1623. [Google Scholar] [CrossRef]
- Dias, A.; Samaranayake, L.; Lee, M. Miconazole lacquer in the treatment of denture stomatitis: Clinical and microbiological findings in Chinese patients. Clin.Oral Investig. 1997, 1, 47–52. [Google Scholar] [CrossRef]
- Parvinen, T.; Kokko, J.; Yli-Urpo, A. Miconazole lacquer compared with gel in treatment of denture stomatitis. Eur. J. Oral Sci. 1994, 102, 361–366. [Google Scholar] [CrossRef] [PubMed]
- Steinberg, D.; Friedman, M. Sustained-release delivery of antimicrobial drugs for the treatment of periodontal diseases: Fantasy or already reality? Periodontol. 2000 2020, 84, 176–187. [Google Scholar] [CrossRef] [PubMed]
- Friedman, M.; Steinberg, D. Sustained-release delivery systems for treatment of dental diseases. Pharm. Res. 1990, 7, 313–317. [Google Scholar] [CrossRef]
- Steinberg, D.; Friedman, M. Sustained-release drug delivery of antimicrobials in controlling of supragingival oral biofilms. Expert Opin. Drug Deliv. 2017, 14, 571–581. [Google Scholar] [CrossRef]
- Faraj, J.A.; Dorati, R.; Schoubben, A.; Worthen, D.; Selmin, F.; Capan, Y.; Leung, K.; DeLuca, P.P. Development of a peptide-containing chewing gum as a sustained release antiplaque antimicrobial delivery system. AAPS PharmSciTech 2007, 8, E177–E185. [Google Scholar] [CrossRef] [PubMed]
- De Luca, M.P.; Franca, J.R.; Macedo, F.A.F.; Grenho, L.; Cortes, M.E.; Faraco, A.A.G.; Moreira, A.N.; Santos, V.R. Propolis varnish: Antimicrobial properties against cariogenic bacteria, cytotoxicity, and sustained-release profile. BioMed Res. Int. 2014, 2014, 348647. [Google Scholar] [CrossRef] [PubMed]
- Kullberg, B.J.; Arendrup, M.C. Invasive candidiasis. N. Engl. J. Med. 2015, 373, 1445–1456. [Google Scholar] [CrossRef]
- Ozturk, A.; Abdulmajed, O.; Aydin, M. Investigation of antifungal, antibiofilm and anti-filamentation activities of biocides against Candida isolates. Ann. Med. Res. 2020, 27, 2041–2046. [Google Scholar] [CrossRef]
- Ramage, G.; Vande Walle, K.; Wickes, B.L.; López-Ribot, J.L. Standardized method for in vitro antifungal susceptibility testing of Candida albicans biofilms. Antimicrob. Agents Chemother. 2001, 45, 2475–2479. [Google Scholar] [CrossRef]
- Hawser, S.P.; Douglas, L.J. Resistance of Candida albicans biofilms to antifungal agents in vitro. Antimicrob. Agents Chemother. 1995, 39, 2128–2131. [Google Scholar] [CrossRef] [PubMed]
- Brown, A.J.; Odds, F.C.; Gow, N.A. Infection-related gene expression in Candida albicans. Curr. Opin. Microbiol. 2007, 10, 307–313. [Google Scholar] [CrossRef] [PubMed]
- Feldman, M.; Shenderovich, J.; Lavy, E.; Friedman, M.; Steinberg, D. A sustained-release membrane of thiazolidinedione-8: Effect on formation of a Candida/Bacteria mixed biofilm on hydroxyapatite in a continuous flow model. BioMed Res. Int. 2017, 2017, 3510124. [Google Scholar] [CrossRef] [PubMed]
- Cervi, V.F.; Saccol, C.P.; da Rosa Pinheiro, T.; Santos, R.C.V.; Sari, M.H.M.; Cruz, L. A novel nanotechnological mucoadhesive and fast-dissolving film for vaginal delivery of clotrimazole: Design, characterization, and in vitro antifungal action. Drug Deliv. Transl. Res. 2022. [Google Scholar] [CrossRef] [PubMed]
- Higuchi, T. Physical chemical analysis of percutaneous absorption process from creams and ointments. J. Soc. Cosmet. Chem. 1960, 11, 85–97. [Google Scholar]
- Higuchi, T. Rate of release of medicaments from ointment bases containing drugs in suspension. J. Pharm. Sci. 1961, 50, 874–875. [Google Scholar] [CrossRef]

| Materials | SRV-CBD/Triclosan | SRV-CBD | SRV-Triclosan | SRV-Placebo |
|---|---|---|---|---|
| CBD | 18.09% | 22.09% | - | - |
| Triclosan | 18.09% | - | 22.09% | - |
| Klucel® EF | 18.29% | 22.33% | 22.33% | 28.66% |
| PEG 400 | 9.04% | 11.04% | 11.04% | 14.17% |
| Eudragit® E | 36.48% | 44.54% | 44.54% | 57.17% |
Publisher’s Note: MDPI stays neutral with regard to jurisdictional claims in published maps and institutional affiliations. |
© 2022 by the authors. Licensee MDPI, Basel, Switzerland. This article is an open access article distributed under the terms and conditions of the Creative Commons Attribution (CC BY) license (https://creativecommons.org/licenses/by/4.0/).
Share and Cite
Feldman, M.; Gati, I.; Sionov, R.V.; Sahar-Helft, S.; Friedman, M.; Steinberg, D. Potential Combinatory Effect of Cannabidiol and Triclosan Incorporated into Sustained Release Delivery System against Oral Candidiasis. Pharmaceutics 2022, 14, 1624. https://doi.org/10.3390/pharmaceutics14081624
Feldman M, Gati I, Sionov RV, Sahar-Helft S, Friedman M, Steinberg D. Potential Combinatory Effect of Cannabidiol and Triclosan Incorporated into Sustained Release Delivery System against Oral Candidiasis. Pharmaceutics. 2022; 14(8):1624. https://doi.org/10.3390/pharmaceutics14081624
Chicago/Turabian StyleFeldman, Mark, Irith Gati, Ronit Vogt Sionov, Sharonit Sahar-Helft, Michael Friedman, and Doron Steinberg. 2022. "Potential Combinatory Effect of Cannabidiol and Triclosan Incorporated into Sustained Release Delivery System against Oral Candidiasis" Pharmaceutics 14, no. 8: 1624. https://doi.org/10.3390/pharmaceutics14081624
APA StyleFeldman, M., Gati, I., Sionov, R. V., Sahar-Helft, S., Friedman, M., & Steinberg, D. (2022). Potential Combinatory Effect of Cannabidiol and Triclosan Incorporated into Sustained Release Delivery System against Oral Candidiasis. Pharmaceutics, 14(8), 1624. https://doi.org/10.3390/pharmaceutics14081624

